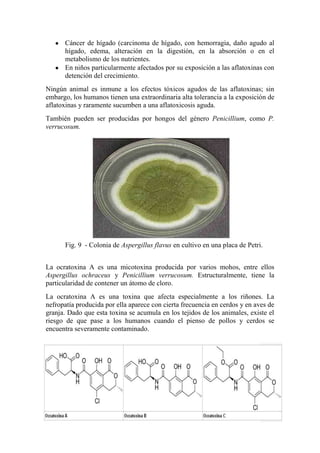
Cáncer de hígado (carcinoma de hígado, con hemorragia, daño agudo al
hígado, edema, alteración en la digestión, en la absorción o en el
metabolismo de los nutrientes.
En niños particularmente afectados por su exposición a las aflatoxinas con
detención del crecimiento.
Ningún animal es inmune a los efectos tóxicos agudos de las aflatoxinas; sin
embargo, los humanos tienen una extraordinaria alta tolerancia a la exposición de
aflatoxinas y raramente sucumben a una aflatoxicosis aguda.
También pueden ser producidas por hongos del género Penicillium, como P.
verrucosum.
La ocratoxina A es una micotoxina producida por varios mohos, entre ellos
Aspergillus ochraceus y Penicillium verrucosum. Estructuralmente, tiene la
particularidad de contener un átomo de cloro.
La ocratoxina A es una toxina que afecta especialmente a los riñones. La
nefropatía producida por ella aparece con cierta frecuencia en cerdos y en aves de
granja. Dado que esta toxina se acumula en los tejidos de los animales, existe el
riesgo de que pase a los humanos cuando el pienso de pollos y cerdos se
encuentra severamente contaminado.
Fig. 9 - Colonia de Aspergillus flavus en cultivo en una placa de Petri.

Este documento describe varias utilidades de los hongos. Explica que los hongos comestibles como Agaricus bisporus y varias especies de Boletus se usan comúnmente como alimento. También señala que algunos hongos tienen usos ornamentales o rituales. Además, detalla que ciertos hongos como algunas especies de Aspergillus, Penicillium y Fusarium pueden contaminar alimentos y causar enfermedades debido a la producción de micotoxinas. Finalmente, menciona que algunos hongos venenosos represent